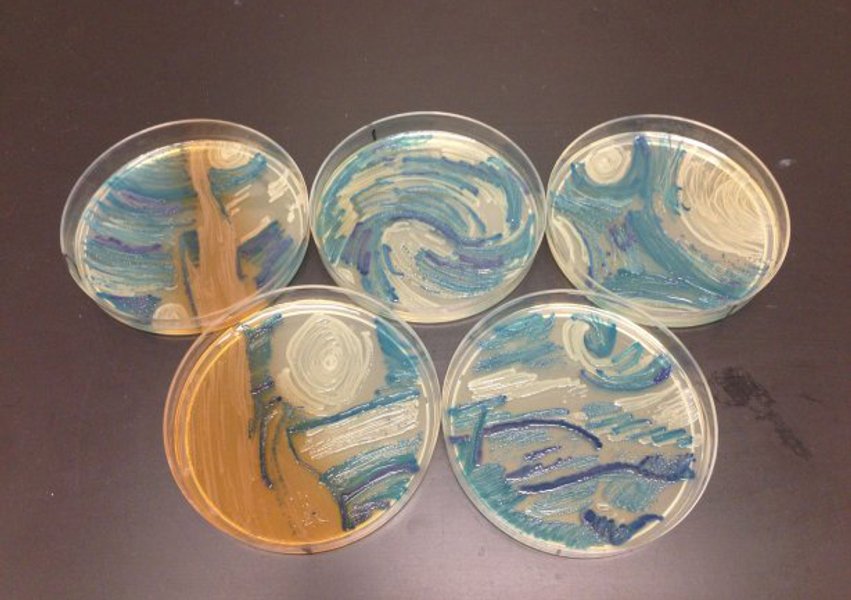
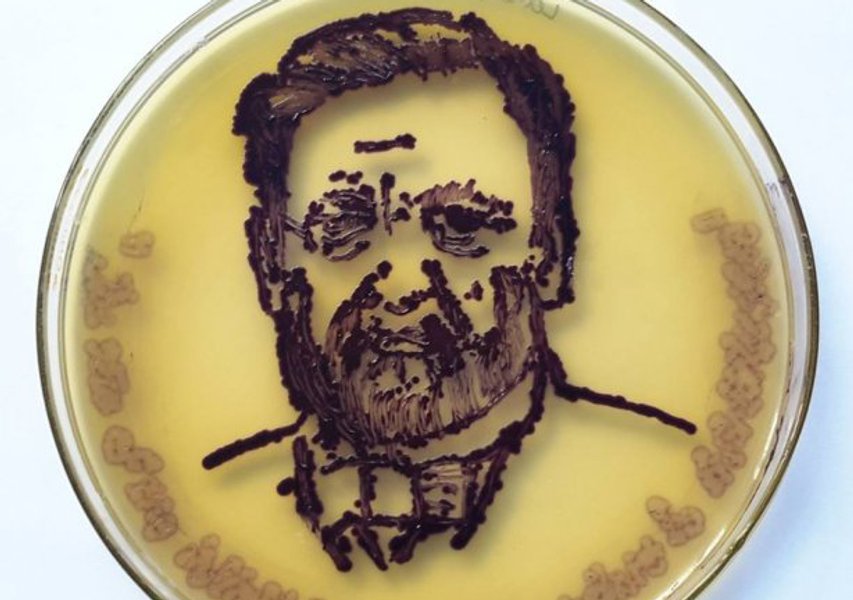

Мир

Фото: Facebook/American Society for Microbiology
В США провели конкурс картин, нарисованных бактериями

Участники изображали животных, портреты и цветы
Американское сообщество микробиологов провело конкурс First Agar Art contest, на котором были представлены картины, созданные из бактерий, сообщает "Зеркало недели".
В качестве холста использовалась чашка Петри, наполненная питательной средой из агар-агара, а в качестве красок – колонии бактерий.
Первое место в конкурсе досталось Марии Пенил. С помощью бактерий она изобразила нейроны.
- СМОТРИТЕ ТАКЖЕ: Американцы построят в пустыне город-призрак стоимостью $1 млрд
Фото: Facebook/American Society for Microbiology
Напомним, недавно украинские ученые в чашке Петри создали портрет Моны Лизы из микробов методом фотопереключения.
Відео дня